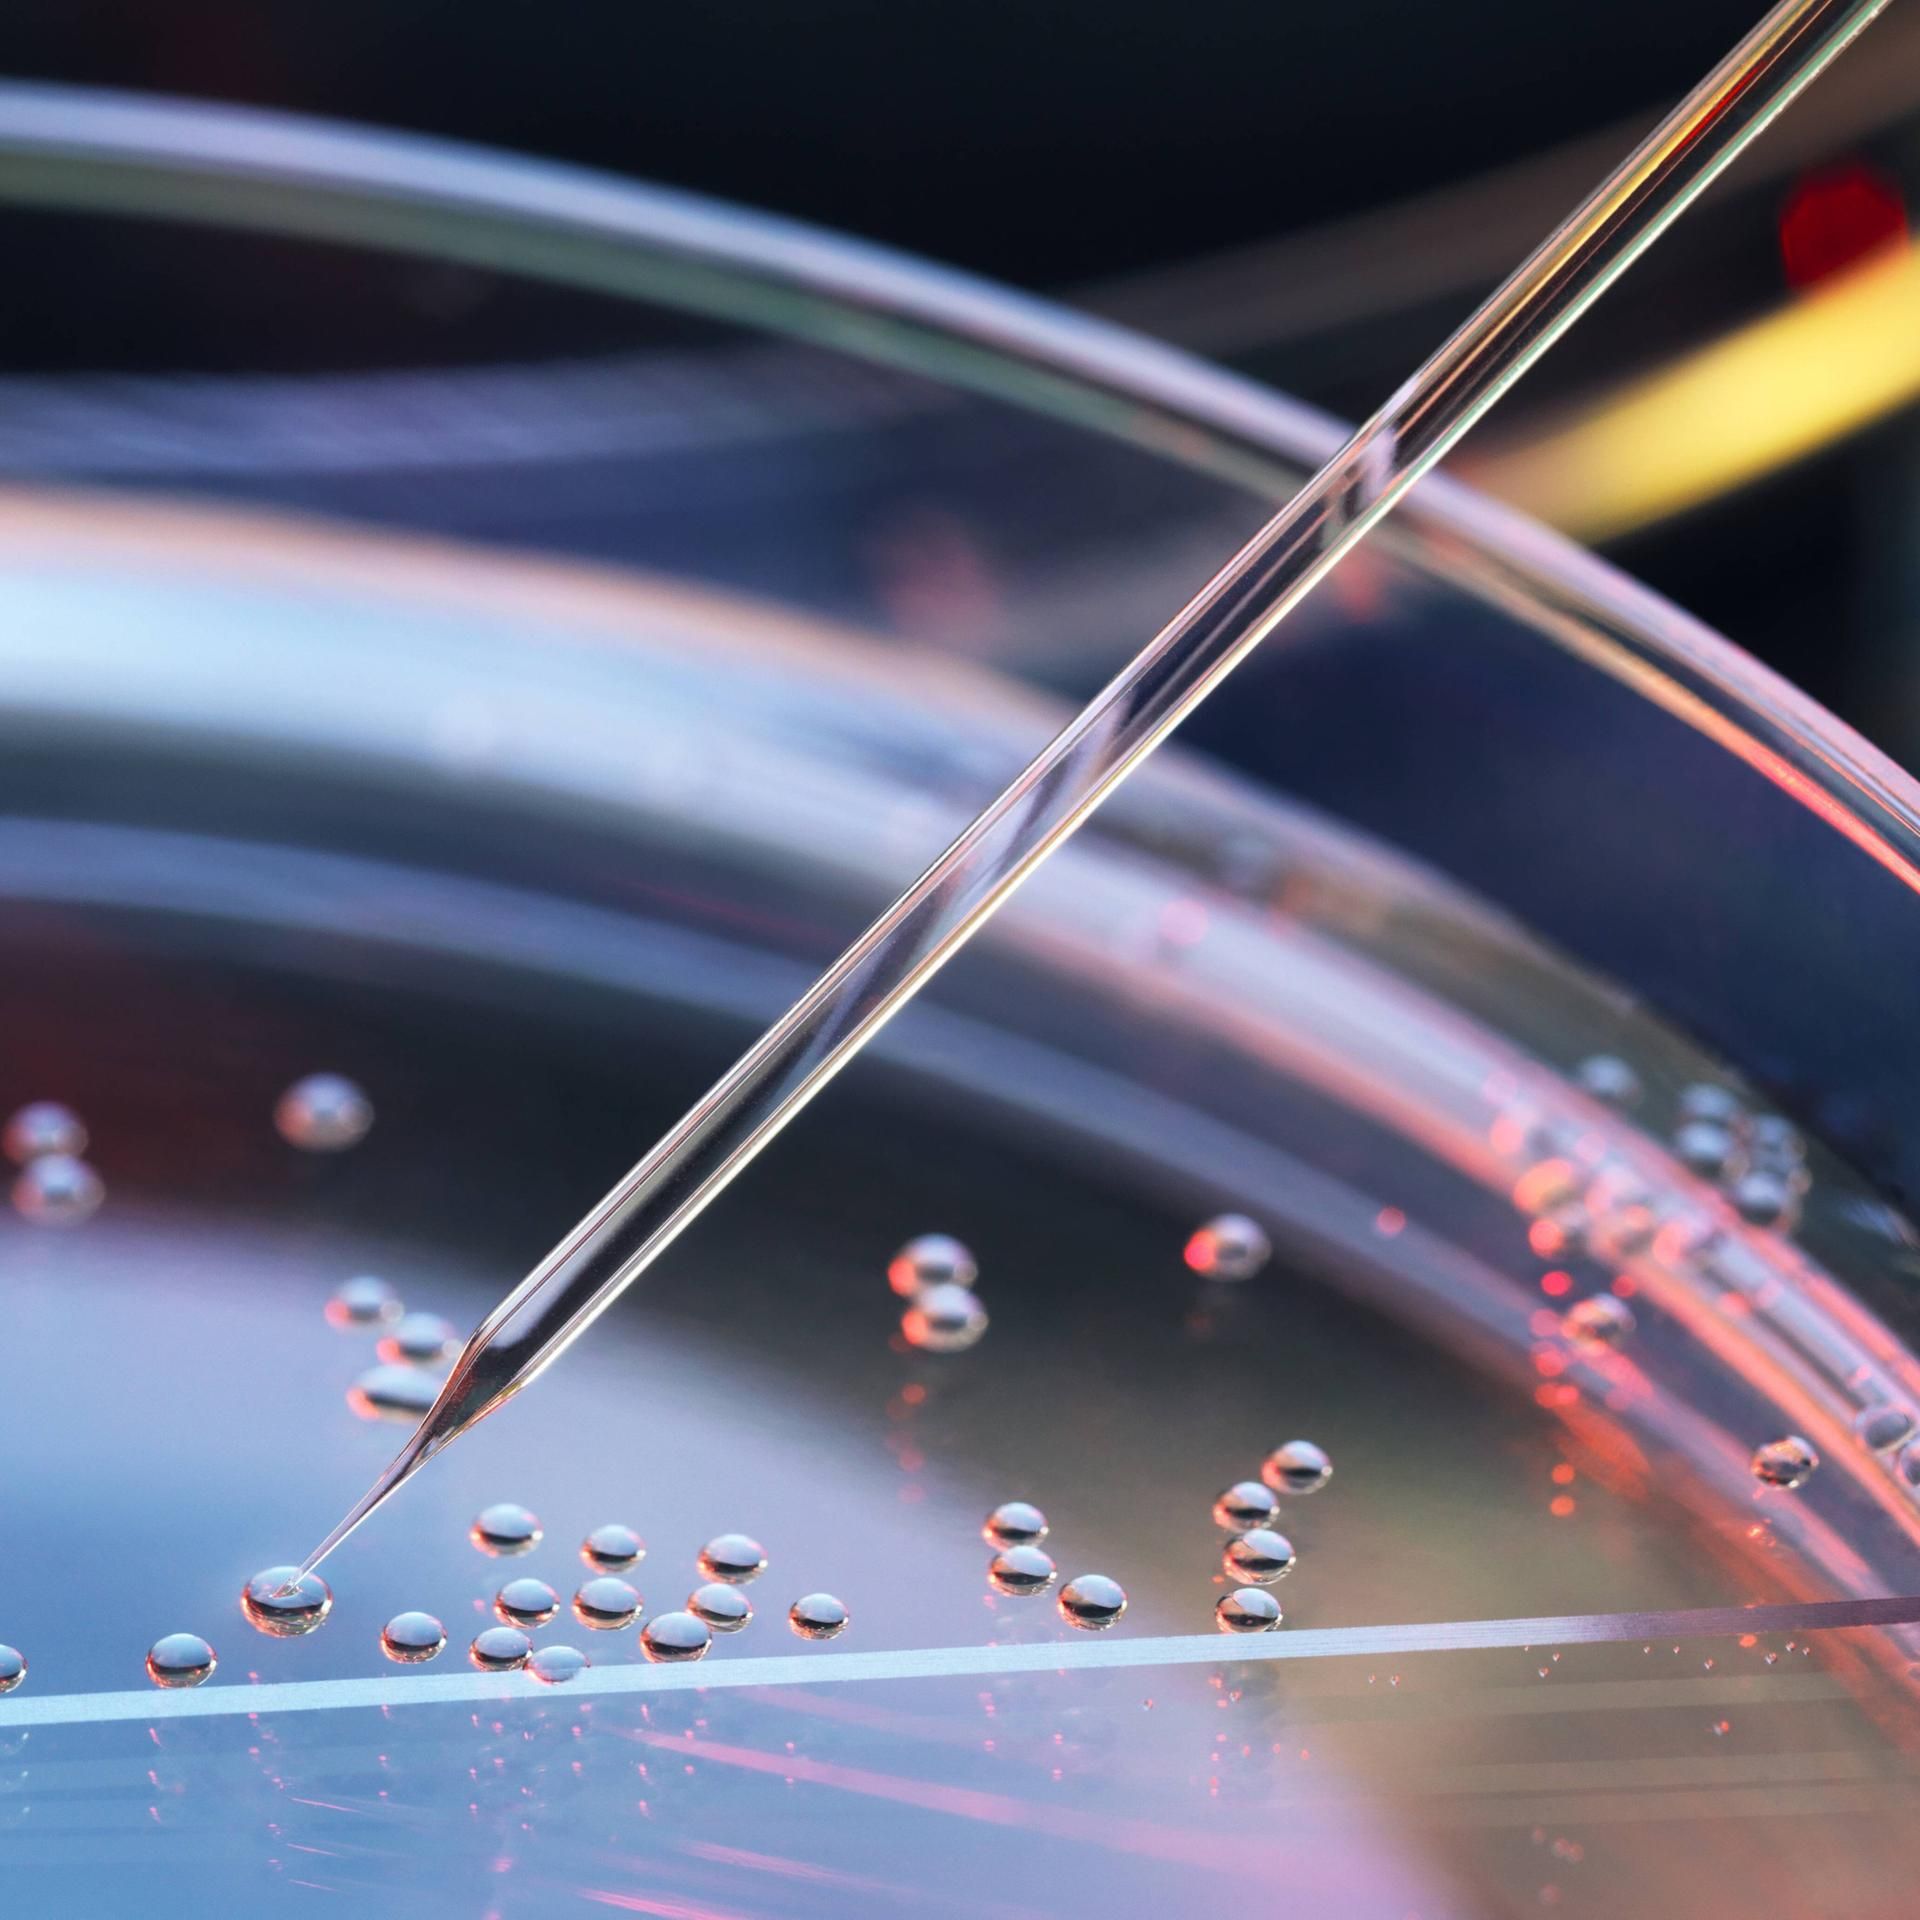

Lange her, aber nicht vorbei: Jede Woche stellen wir Fragen der Gegenwart und suchen Antworten in der Geschichte. Ob Nahostkonflikt, Reichsbürger oder Trumps Amerika - wir liefern das historische Wissen, um die Debatten von heute zu verstehen.
Alle Folgen
Myanmar - Im Griff des Militärs
In Myanmar herrscht Bürgerkrieg. Jetzt soll gewählt werden, doch das dürfte eine Show-Veranstaltung des Militärs sein. Seit der Unabhängigkeit 1948 gibt es im Land gewaltsame Konflikte. Das hängt auch mit der britischen Kolonialgeschichte zusammen. Biesler, Jörg

Podcast-Tipp - Die Psychonauten - und DRiG auf Tournee!
Euer Geschichtspodcast "Der Rest ist Geschichte" macht diese Woche Pause. Aber wir empfehlen Euch die "Psychonauten", das ist die neuste Staffel von "Deep Science". Außerdem haben wir noch ein paar Termine für Euch: Ihr könnt DRiG live erleben! Tran, Anh

Mao - Chinas Messias und Massenmörder
Mao Zedong rief 1949 die Volksrepublik China aus. Für den kommunistischen Umbau des riesigen Landes nahm er Millionen Todesopfer in Kauf. Doch der Mao-Kult ist in China noch immer lebendig und prägt die Politik des heutigen Präsidenten Xi Jinping. Biesler, Jörg

Rechter Terror - Das Gift der Verharmlosung
NSU, Baseballschlägerjahre, Oktoberfestattentat: Die Bundesrepublik hat eine lange und blutige Geschichte des Rechtsterrorismus. Die Gewalt konnte auch deshalb gedeihen, weil Polizei und Behörden oft falschen Fährten folgten. Tran, Anh

Venezuela - Im Fadenkreuz der USA
Kriegsschiffe in der Karibik: Die USA drohen dem linken Regime in Caracas. Diktator Nicolás Maduro könnte davon allerdings profitieren, denn das amerikanische Säbelrasseln belebt ein historisches Motiv in Venezuela: die Befreiung von fremden Mächten. Biesler, Jörg

Die Schweiz - Kampf um Neutralität
Die Schweiz liefert keine Waffen an die überfallene Ukraine, denn als neutraler Staat hält sie sich aus Kriegen raus. Ob das jahrhundertealte Prinzip der Neutralität reformiert werden sollte, darüber wird in der Schweiz gerade gestritten. Biesler, Jörg

Horror und Halloween - Die Lust am Grusel
Blut aus der Tube, Kürbis-Fratzen und im Garten klapprige Skelette: So ist Halloween! Das Fest hat keltische Ursprünge. Geschichten von Monstern und Ungeheuern sind so alt wie die Menschheit, doch echten Horror gibt es erst seit dem 18. Jahrhundert. Biesler, Jörg

Podcast-Tipp - "Crashkurs": Die Rettung der Ozonschicht
Euer Geschichtspodcast „Der Rest ist Geschichte“ macht diese Woche Pause! Aber wir empfehlen euch den Podcast „Crashkurs" mit Themen aus der Wirtschaftsgeschichte. In dieser Folge geht es um die Rettung der Ozonschicht. Pfister, Sandra

Todesstrafe - Kreuzigen, steinigen, enthaupten, erschießen, erhängen, vergiften
Die Zahl der Hinrichtungen ist so hoch wie lange nicht; obwohl viele Staaten die Todesstrafe in den vergangenen Jahrzehnten abgeschafft haben. Menschen mit dem Tod zu bestrafen, hat eine lange Geschichte – nur die Methoden haben sich verändert. Tran, Anh

Obdachlosigkeit - Abgestempelt als "asozial"
Bis 2030 soll jeder Mensch in der Europäischen Union ein Dach über dem Kopf haben. Doch dieses EU-Ziel dürfte unerreichbar sein. Die Geschichte zeigt: Obdachlosigkeit hält sich hartnäckig, die damit verbundene Abwertung auch. Tran, Anh

Österreich - Phantomschmerz eines untergegangenen Weltreichs
Österreich war einst ein mächtiges Imperium. Heute ist es ein kleiner EU-Staat mit einer mächtigen rechten Partei. Historiker sagen: Das eine hat mit dem anderen zu tun. Man erinnert sich halt lieber an die Monarchie als an Nazi-Schuld. Biesler, Jörg

Krieg und Frieden - Was nutzt Pazifismus?
Wenn die Gegenseite Krieg will, hilft Friedensliebe wenig. Pazifisten gelten heute als Träumer, Populisten oder Putin-Versteher. Tatsächlich hatte die Friedensbewegung ihre beste Zeit, als der Krieg weit weg war. Wirkungslos war sie deshalb nicht. Tran, Anh

Geschichtsfälschungen - War Hitler links?
Nein, war er nicht. Doch in rechten Kreisen hört man diese Lüge neuerdings wieder öfter: Die Nationalsozialisten seien links gewesen, schon allein wegen der „Sozialisten“ im Namen. Wer das erzählt, verfolgt damit ein bestimmtes Ziel. Biesler, Jörg

Tschetschenien - Drehbuch der Unterwerfung
Russlands Präsident Putin hat sich die Kaukasusrepublik Tschetschenien gefügig gemacht: Er hat den Ruf nach Unabhängigkeit im Krieg erstickt und dem brutalen Kadyrow-Clan zur Macht verholfen. Tschetscheniens Geschichte könnte zur Blaupause werden. Tran, Anh

Völkerstrafrecht - Kriegsverbrecher auf der Anklagebank
Nürnberg 1945: Hochrangige Nationalsozialisten müssen sich vor einem internationalen Militärgericht verantworten. Der Prozess gilt als Markstein des Völkerstrafrechts. Doch bis heute ist es schwierig, Kriegsverbrecher zu belangen. Kuban, Josephine

Oligarchien - Mächtige Milliardäre
Die USA gelten als älteste Demokratie der Welt – doch unter Donald Trump fürchten viele den Aufstieg von Oligarchen. Was bedeutet das? Die Geschichte verheißt nichts Gutes: vom antiken Griechenland bis zur Ausbeutung der sterbenden Sowjetunion. Biesler, Jörg

Vergewaltigung im Krieg - Eine Waffe, die für immer verletzt
Soldaten kämpfen. Soldaten verteidigen. Und manche Soldaten vergewaltigen. Kriege ohne sexualisierte Gewalt gab es vermutlich nie, oft wird sexuelle Folter sogar zu einer eigenen Waffe. Die Anerkennung als Kriegsverbrechen kam spät. Peetz, Katharina

Josef Stalin - Er ist wieder da
Der sowjetische Diktator Josef Stalin war ein Tyrann und Massenmörder, verantwortlich für Deportationen, Erschießungen und Hungersnöte. Doch heute wird er in Russland wieder verehrt, nicht nur mit neuen Denkmälern. Was steckt hinter dem Stalin-Kult? Biesler, Jörg

Zweiter Weltkrieg - Japans Schmerz und Japans Schuld
Zwei amerikanische Atombomben brachten im August 1945 unvorstellbares Leid über Japan und setzten dem Weltkrieg auch in Asien ein Ende. Die Erinnerung an das Inferno behindert in Japan bis heute die Aufarbeitung von Kriegsschuld und Kriegsverbrechen. Tran, Anh

Wehrpflicht - Warum die Deutschen sich schwertun mit Bürgern als Soldaten
Die Bundesregierung sucht händeringend Personal für die Bundeswehr, will die Wehrpflicht aber erst einmal nicht wieder aktivieren. In der deutschen Geschichte ist die Wehrpflicht bereits mehrfach eingeführt und wieder ausgesetzt worden. Biesler, Jörg

Podcast-Tipp - Der neue Westen - Gespräche zur Weltlage
"Der Rest ist Geschichte" macht diese Woche Pause! Für die Zwischenzeit empfehlen wir Euch das Format "Der neue Westen" mit Gesprächen zur Weltlage. In Folge #14 antwortet der Politologe Herfried Münkler auf die Frage: Hat der Westen eine Zukunft? Dittrich, Monika

Die Bahn - Es war einmal eine Zukunftstechnologie
Der Zug zu spät, das Klo verstopft, der Schaffner blöd: Die Bahn regt heute viele auf. Vor 200 Jahren war die Eisenbahn ein Motor des Fortschritts – und sie fuhr sogar profitabel. Dann kamen Kriege, Konkurrenten und Fehlentscheidungen. Tran, Anh

Kaschmir-Konflikt - Säbelrasseln im Paradies
Atemberaubende Landschaft, Himalaya-Gipfel, saftige Täler: Touristen bezeichnen Kaschmir oft als „Paradies auf Erden“. Doch die Region ist umkämpft: Die Atommächte Indien und Pakistan ringen hier um Einfluss. Der Konflikt hat eine lange Geschichte. Biesler, Jörg

Krebs - Der Angstgegner
Seit Jahrtausenden erkranken Menschen an Krebs. Die längste Zeit konnten Ärzte nichts dagegen tun: Ihre Patienten starben qualvoll. Vor allem im 20. Jahrhundert wurden wirksame Therapien entwickelt. Doch Krebs bleibt eine häufige Todesursache. Tran, Anh

Bürokratie - Mag keiner, braucht jeder
Das Römische Reich wäre nicht groß und mächtig geworden ohne Bürokratie. Staaten brauchen Verwaltung – und auch Bürger profitieren davon. Zur Wahrheit gehört aber auch: Bürokratie hat das größte Verbrechen der Menschheitsgeschichte erst ermöglicht. Biesler, Jörg

Öffentlich-Rechtliche - "Staatsferne" war neu für die Deutschen
Zu links, zu teuer, zu behäbig: Es gibt Kritik am öffentlich-rechtlichen Rundfunk. Entstanden sind die Sender nach 1945 auf Wunsch der West-Alliierten – zum Schutz der Demokratie. In der jungen Bundesrepublik fanden das nicht alle gut. Tran, Anh

Queere Geschichte - Liebe, Sex und Konzentrationslager
Selbst im Westen sind queere Menschen wieder in Gefahr: Rechtspopulisten und autoritäre Politiker wettern gegen "Gendergaga". Für ihre Gleichberechtigung haben Schwule, Lesben und Transpersonen lange gekämpft, manche bezahlten dafür mit dem Leben. Tran, Anh

Israels rechte Siedler - Boden und Bibel
Israel will den Gazastreifen dauerhaft besetzen. Was als Verteidigung gegen den Terror der Hamas begann, ist aus Sicht radikaler jüdischer Siedler die Chance, ihr Land zu vergrößern. Sie berufen sich auf Gott und Geschichte. Biesler, Jörg

Geschichte der Türkei - Das Erbe einer Modernisierungsdiktatur
Krisen und Protesten zum Trotz: Präsident Recep Tayyip Erdoğan hält sich in der Türkei seit mehr als 20 Jahren an der Macht. Seine Vision ist eine Türkei in der Tradition des Osmanischen Reichs, sein Vorbild ein Sultan aus dem 19. Jahrhundert. Tran, Anh

Podcast-Tipp - "Wissenschaft im Brennpunkt" - Drohnenkrieg und Nerventerror
"Der Rest ist Geschichte" macht diese Woche Pause! Für die Zwischenzeit empfehlen wir Euch das Format "Wissenschaft im Brennpunkt" mit einer Folge über den Sound moderner Kampfdrohnen und wie der sich in den Köpfen seiner Opfer festsetzt. Guckelsberger, Florian

US-Zölle - Alles schon mal da gewesen
Zölle rauf, Zölle runter: Die Handelspolitik von US-Präsident Donald Trump wirkt chaotisch. Er will die amerikanische Wirtschaft schützen und andere Länder bestrafen. Diese Politik hat Tradition in den USA – und sie war auch mal erfolgreich. Biesler, Jörg

Nach dem Holocaust (4/4) - "Der 8. Mai war ein Tag der Befreiung"
Wie ist das Ende des Zweiten Weltkriegs 1945 zu bewerten? Der Sieg der Alliierten über die Nazi-Herrschaft war für die Deutschen auch eine Niederlage, aber nicht nur. Vor 40 Jahren fand Bundespräsident Richard von Weizsäcker die richtigen Worte. Biesler, Jörg

Nach dem Holocaust (3/4) - Nazi-Vergangenheit? Gab es nicht in der DDR
Die DDR verstand sich als antifaschistischer Staat, bevölkert von kommunistischen Widerstandskämpfern. Die Geschichte des Nationalsozialismus schob man der Bundesrepublik zu. An jüdische Opfer wurde in der DDR so gut wie gar nicht erinnert. Tran, Anh

Nach dem Holocaust (2/4) - Die Wucht einer Fernsehserie
Im Januar 1979 hängen Millionen Bundesbürger vor ihren Fernsehern. Sie schauen die US-Serie "Holocaust" - und viele von ihnen sind schockiert und aufgerüttelt. Die Serie sollte die Debatte über NS-Verbrechen verändern. Tran, Anh

Nach dem Holocaust (1/4) - Das Grauen vor Gericht
Als 1963 der erste große Auschwitz-Prozess begann, saß eigentlich eine ganze Nation auf der Anklagebank: Es war der Versuch, das Menschheitsverbrechen Holocaust juristisch aufzuarbeiten. Teil eins der Serie über Wendepunkte der Erinnerung. Biesler, Jörg

Das Konklave - Wie Priester zu Päpsten werden
Wenn ein neuer Papst gesucht wird, kommen die Kardinäle der katholischen Kirche im Vatikan zu einem Konklave zusammen. Bis heute haben die Papstwahlen etwas Geheimnisvolles - früher waren sie manchmal auch lebensgefährlich. Tran, Anh

Der 8. Mai (6/6) - Das Wunder der deutsch-französischen Aussöhnung
Kriege und Gewalt prägten das Verhältnis zwischen Deutschland und Frankreich über lange Zeit. Heute gilt die deutsch-französische Freundschaft als Motor Europas. Wie konnte das gelingen nach so viel Blutvergießen? Letzte Folge der Serie. Biesler, Jörg

Der 8. Mai (5/6) - Großbritannien - Nach dem Bombenkrieg kam die Beatlemania
Die Briten haben den Nazis im Zweiten Weltkrieg erbitterten Widerstand geleistet, sie haben enorme Opfer gebracht – und die Deutschen schließlich mit den Alliierten besiegt. Bei der Aussöhnung nach 1945 halfen Queen und Popkultur. Biesler, Jörg

Der 8. Mai (4/6) - Deutsche, Tschechen und die Last der Vergangenheit
Die Tschechoslowakei erlebte in der Nazi-Zeit entsetzlichen Terror: verraten von Verbündeten, von Hitler zerschlagen, von Deutschen tyrannisiert. Nach dem Weltkrieg reagierten die Tschechen mit wilder Vertreibung. Folge vier der Serie. Tran, Anh

Der 8. Mai (3/6) - Versöhnung auf Dänisch
Nach dem Ende des Zweiten Weltkriegs hätten die Dänen Gebiete von Deutschland bekommen können. Wollten sie aber nicht. Stattdessen kümmerten sie sich um deutsche Flüchtlinge – und das nach Jahren der Besatzung. Folge drei der Serie. Biesler, Jörg

Der 8. Mai (2/6) - Niederlande - Wunden, Wut und späte Selbstkritik
Die Terrorherrschaft der Nazis hat die Niederlande geprägt: Nirgendwo sonst in Westeuropa gab es so viele jüdische Holocaust-Opfer. Nach dem Krieg dominierte Pragmatismus, erst spät begann die Debatte über eigene Verantwortung. Teil zwei der Serie. Tran, Anh

Der 8. Mai (1/6) - Kriegsende in Polen - bittere Befreiung
80 Jahre nach dem Ende des Zweiten Weltkriegs schauen wir in einer Serie auf unsere Nachbarn: Wie haben sie es geschafft, die Deutschen wieder zu ertragen – nach Hitler und Holocaust? Folge eins: Polen. Biesler, Jörg

Sudan - "Ein ignorierter Krieg"
Diktator Omar al-Baschir hat den Sudan 30 Jahre lang unterjocht. Als er 2019 gestürzt wurde, schienen Demokratie und Frieden in dem afrikanischen Land zum Greifen nah. Doch nun herrscht ein blutiger Bürgerkrieg. Er hat eine Vorgeschichte. Biesler, Jörg;Sonja Ernst

Podcast-Tipp - "Der neue Westen" - Gespräche zur Weltlage
Gehören die USA jetzt nicht mehr zum Westen? Auf diese Frage antwortet der Historiker Volker Depkat in der ersten Folge von „Der neue Westen“. Ein neuer Podcast, den wir Euch heute außer der Reihe empfehlen. Dittrich, Monika

Deutsche Zweiheit - Kam die Wiedervereinigung zu schnell?
Vermögen, Tennisplätze, AfD-Wähler: Vieles ist zwischen Ost- und Westdeutschland ungleich verteilt. Die Transformationswunden schmerzen auch noch 35 Jahre nach der Wiedervereinigung. Und manche meinen: Die Einheit kam überstürzt. Biesler, Jörg

Die Kurden - Das größte Volk ohne eigenen Staat
Kurdistan gibt es nicht. Zumindest nicht als Staat. Doch Millionen Kurden im Nahen Osten sehnen sich danach. Ihr historisches Siedlungsgebiet liegt in Syrien, der Türkei, im Irak und Iran. Dort ist die kurdische Geschichte von Verfolgung geprägt. Tran, Anh

Der Balkan - Von fremden Mächten jahrhundertelang umkämpft
Autoritäre Machthaber, nationalistische Abspaltungen und Dauerproteste: Der Balkan ist eine Region mit vielen Krisen und einer blutigen Geschichte. Weltmächte und Diktatoren haben hier um Vorherrschaft gerungen. Das hat Spuren hinterlassen. Biesler, Jörg

Noch nie unabhängig - Wem gehört Grönland?
Donald Trump ist nicht der Erste, der Grönland besitzen will: Die Insel ist strategisch wichtig und reich an Rohstoffen. Schon die Wikinger rangen hier um Einfluss, später wurde kolonisiert und missioniert. Die Rolle Dänemarks als Mutterland ist bis heute umstritten. Biesler, Jörg;Röther, Christian

Podcast-Tipp - "KI verstehen": Künstliche Intelligenz aus China
Euer Geschichtspodcast „Der Rest ist Geschichte“ macht diese Woche Pause! Aber wir empfehlen euch den Podcast „KI verstehen“ über Künstliche Intelligenz im Alltag. In dieser Folge geht es um Deepseek und andere KI-Entwicklungen aus China. Wessel, Felix; Krauter, Ralf

Koalitionen - Lob des Kompromisses
Im Wahlkampf stehen sich die Parteien erbittert gegenüber, nach der Wahl müssen manche von ihnen dann doch zusammenarbeiten: Koalitionsregierungen sind in der Bundesrepublik der Normalfall – und in der Geschichte waren sie oft auch ein Glücksfall. Tran, Anh

Wahlkampf - Stimmen fangen im Plakatewald
Wahlkampf gilt als Hochamt der Demokratie. In kurzer Zeit und krassem Wettbewerb müssen Politiker ihre Absichten erklären. Die Mittel haben sich im Lauf der Geschichte verändert, doch das Ziel ist gleich geblieben: Menschen zur Wahl animieren. Kuban, Josephine

NSDAP, KPD, AfD? - Warum Parteiverbote in Deutschland schwierig sind
Sollte die AfD verboten werden? Eine Gruppe von Bundestagsabgeordneten ist dafür. Entscheiden kann darüber nur das Bundesverfassungsgericht - und die Hürden sind hoch. In der Geschichte der Bundesrepublik wurden erst zwei Parteien verboten. Tran, Anh;Röther, Christian

Adel in der NS-Zeit - Sie liebten Blut und Boden
1919 wurde der Adelsstand in Deutschland abgeschafft. Trotzdem blieben Adelige politisch einflussreich: Viele bekämpften die Demokratie und verhalfen Hitler zur Macht. Über die Rolle des Adels im Nationalsozialismus wird bis heute gestritten. Biesler, Jörg

Baltische Staaten - Mit feindseligen Nachbarn kennen sie sich hier aus
Sollte Russland NATO-Territorium angreifen, dann am ehesten im Baltikum: Das ist die Sorge vieler Menschen in Estland, Lettland und Litauen. Ihre Angst vor russischer Aggression sitzt tief, auch weil sie lange um ihre Unabhängigkeit kämpfen mussten. Tran, Anh

Trumps Amerika - Stresstest für die Demokratie
Und was ist, wenn der Präsident ungeeignet ist? Das fragten sich die Gründerväter der USA. Ihre Antwort vor bald 250 Jahren: Machtkontrolle durch Gewaltenteilung. Unter Donald Trump wird sich zeigen, ob die „Checks and Balances“ noch funktionieren. Biesler, Jörg

Fünf Jahre Corona - Was wir von den Pocken hätten wissen können
Im 19. Jahrhundert sterben in Europa Hunderttausende an den Pocken. Dabei gibt es bereits eine wirksame Impfung. Viele Staaten reagieren mit einer Impfpflicht, was zu heftigen Protesten führt. Die Parallelen zur Coronapandemie sind frappierend. Tran, Anh

Geschichte des Erdöls - Wie wir süchtig wurden
Erdöl ist der Stoff, der die Moderne ermöglicht hat: ein Wundermittel für Fortschritt, Erfindungen und Mobilität. Doch das Verbrennen von Erdöl schadet dem Klima und gefährdet die Menschheit. Wir wissen das. Trotzdem kommen wir nicht davon los. Tran, Anh www.deutschlandfunk.de, Der Rest ist Geschichte

Fäkaliengeschichte - Ach du Scheiße!
Jeder muss mal, das war schon immer so. Was hinten rauskommt, wurde je nach Epoche als Schadstoff oder Rohstoff angesehen. Die alten Ägypter düngten damit ihre Felder, die Römer saßen auf Marmor-Klos, im Mittelalter schwor man auf die Dreck-Apotheke. Biesler, Jörg

Jesus von Nazareth - Die Wahrheit über Leben und Legenden
An Weihnachten feiern Christen die Geburt von Jesus. Die Geschichte mit der Krippe in Bethlehem ist wohl erfunden, der Tod am Kreuz hingegen nicht. Forscher durchleuchten den historischen Jesus, doch sein Leben gibt weiter Rätsel auf. Tran, Anh

Geschichte Syriens - Schlachtfeld der Stellvertreter
Islamistische Rebellen haben Syriens Diktator Assad gestürzt. Jahrzehntelang hatte er sein Volk brutal unterdrückt – mit Schützenhilfe von Russland und Iran. Die Einmischung ausländischer Mächte hat in Syrien eine lange Geschichte. Biesler, Jörg

Hörtipp - Podcast "Die Kunstretter"
"Der Rest ist Geschichte" macht diese Woche Pause! Für die Zwischenzeit empfehlen wir Euch den Podcast "Die Kunstretter". Darin geht es um Menschen in der Ukraine, die die Kunstschätze ihres Landes vor dem russischen Angriffskrieg schützen wollen. Gorgis, Elena

"Reichsbürger" - Sie träumen vom Reich. Aber von welchem?
Die Bundesrepublik sei kein souveräner Staat und noch immer von Alliierten besetzt: Das glauben sogenannte Reichsbürger. Sie deuten die Geschichte um und sehnen sich nach einem Deutschen Reich. Das ist nicht nur bizarr, sondern auch gefährlich. Biesler, Jörg

Geschichte der Ehe - Kirche, Staat und Sex
Spießig, kleinbürgerlich, altmodisch: Die Ehe hatte schon oft einen schlechten Ruf. Geheiratet wird trotzdem, und das schon seit Ewigkeiten. Dabei war die Ehe nie nur Sache von zwei Leuten - Politik und Kirche haben immer mitgemischt. Pulz, Magdalena

Die Huthi im Jemen - Terror am Tor der Tränen
Huthi-Kämpfer im Jemen drangsalieren Zivilisten, sie überfallen Handelsschiffe im Roten Meer und feuern Raketen auf Israel. Die Ideologie der schiitischen Miliz ist eng mit der blutigen Geschichte des Landes verbunden. Biesler, Jörg

Nordkorea - Die verschlossene Diktatur
Nordkoreas Herrscher posiert mit dicken Raketen, sein Volk lässt er hungern und jetzt müssen seine Soldaten für Russland kämpfen. Säbelrasseln, Abschottung und Personenkult haben in Nordkorea eine lange Geschichte. Biesler, Jörg

USA-Bonusfolge (3/3) - Barack Obama: Der Begeisternde
Mit dem Slogan „Yes We Can“ euphorisierte Barack Obama seine Anhänger. Die Erwartungen an den ersten Schwarzen US-Präsidenten waren riesig und kaum erfüllbar. Umso schockierter waren viele, als auf Obama ausgerechnet Donald Trump folgte. Biesler, Jörg

USA-Bonusfolge (2/3) - Richard Nixon: Der Gefallene
Er ist bis heute der einzige amerikanische Präsident, der zurücktreten musste: Richard Nixon stürzte über die Watergate-Affäre. Das ruhmlose Ende seiner Präsidentschaft überschattet seine politischen Verdienste – von Abrüstung bis Umweltschutz. Biesler, Jörg

USA-Bonusfolge (1/3) - John F. Kennedy: Der Unsterbliche
Noch vor Ende der ersten Amtszeit starb John F. Kennedy bei einem Attentat. Er war nur 1.000 Tage lang US-Präsident. Doch die Erinnerung an ihn ist in den USA hellwach: an den brillanten Redner, den visionären Politiker - und den Mann mit Schwächen. Biesler, Jörg

USA-Spezial (4/4) - Was aus dem American Dream geworden ist
Wer hart genug arbeitet, kann es vom Tellerwäscher zum Millionär bringen: Das ist der „American Dream“, ein Aufstiegsversprechen, das die Mentalität der USA seit Generationen prägt. Die historische Idee war allerdings größer. Letzter Teil der Serie. Pulz, Magdalena

USA-Spezial (3/4) - Warum den Amerikanern das Waffenrecht heilig ist
50.000 Menschen sterben in den USA im Jahr durch Schusswaffen. Für amerikanische Kinder sind Schussverletzungen Todesursache Nummer eins. Trotzdem halten die USA an ihrem historischen Waffenrecht fest. Spinnen die Amis? Teil drei unserer Serie. Biesler, Jörg

USA-Spezial (2/4) - Warum Religion in der amerikanischen Politik wichtig ist
Im US-Wahlkampf hört man ständig: „God bless America!“ Religion ist in den USA so wichtig wie in keinem anderen westlichen Land. Das hat historische Gründe. Doch die Religionsgeschichte der USA beginnt in Europa. Teil zwei der Serie. Pulz, Magdalena

USA-Spezial (1/4) - Wie Amerika Weltmacht wurde
Der deutsche Blick auf die USA ist geprägt von Bewunderung, Kritik und Klischees. Manche fragen sich: Spinnen die Amis? In dieser Serie liefern wir historische Erklärungen für transatlantische Missverständnisse. Folge eins: Amerika als Weltpolizist. Biesler, Jörg

Wissenschaftsfreiheit - Nix für Diktatoren
In Deutschland steht die Wissenschaftsfreiheit im Grundgesetz - das verdanken wir auch den Revolutionären von 1848. Heute sehen manche dieses Grundrecht in Gefahr: Sie meinen, dass bei Themen wie Corona, Gender oder Klima nicht frei geforscht wird. Tran, Anh

Israels Geheimdienst - "Das kann nur der Mossad"
Explodierende Kommunikationsgeräte bei Hisbollah-Kämpfern im Libanon: Dafür soll der Mossad verantwortlich sein. Der israelische Geheimdienst ist eng mit der Geschichte des jüdischen Staates verbunden. Seine Methoden sind so umstritten wie legendär. Biesler, Jörg

Von Mussolini zu Meloni - Hat der Faschismus in Italien überlebt?
Italien wird von der ultrarechten Giorgia Meloni regiert. Sie wird auch als Postfaschistin bezeichnet. Vom historischen Mussolini-Faschismus distanziert sie sich. Doch ihre Kritiker glauben ihr nicht. Pulz, Magdalena

Geschichte des Eigentums - Freiheit, Gleichheit, Habseligkeit
Über die Verteilung von Vermögen wird viel gestritten. Was heute kaum vorstellbar ist: Einst war die Idee individuellen Eigentums radikal. Die Französische Revolution forderte nicht nur das Ende des Feudalismus, sondern auch - Eigentum für alle! Biesler, Jörg

Geschichte der TV-Duelle - Macht der Mattscheibe
Der eine schwitzt, der andere glänzt: Richard Nixon und John F. Kennedy traten 1960 in einer Fernsehdebatte an - es war die Geburtsstunde des TV-Duells. Das Format gibt es heute auf der ganzen Welt, doch die Vorgeschichte ist älter als das Fernsehen. Pulz, Magdalena

Religiöse Herrschaft - Was Islamisten meinen, wenn sie ein Kalifat fordern
Der „Islamische Staat“, der sich zum Messeranschlag von Solingen bekannt hat, will ein Kalifat errichten – also einen islamischen Gottesstaat. Die Ideen des IS haben mit den historischen Kalifaten allerdings wenig zu tun. Pulz, Magdalena

Klima und Krise - Seit wann wir von der Erderwärmung wissen
Jetzt spüren wir, wie sich Klimawandel anfühlt: Städte werden im Sommer zu Backöfen, Dörfer ertrinken im Regen, Eisbären schmilzt das Eis weg. All das wurde lange vorhergesagt. Doch die Geschichte des Klimawandels ist eine Geschichte des Wegsehens. Biesler, Jörg www.deutschlandfunk.de, Der Rest ist Geschichte

Frankreich und wir - Wie aus Feinden Freunde wurden
Kriege, Gewalt und Rivalität prägten das Verhältnis zwischen Deutschland und Frankreich über lange Zeit. Heute ist das anders: Die deutsch-französische Freundschaft gilt als Motor Europas. Wie konnte das gelingen nach so viel Blutvergießen? Biesler, Jörg

Geschichte der Schule - Hefte raus, Bildungsreform!
Die Schule ist ein Zankapfel: Was sollen Kinder lernen, wie sinnvoll sind Noten, welche Chancen haben Schüler aus armen Familien? Darüber streiten Politiker, Eltern, Experten. Neu ist das nicht. Manche Debatte wurde schon im 19. Jahrhundert geführt. Pulz, Magdalena

Raumfahrt - Krieg der Systeme
China schickt Sonden zum Mond, die NASA trainiert für den Mars, Europa startet eine Ariane-Rakete: Wer den Weltraum beherrscht, profitiert auf der Erde. Der Wettlauf im All ist so alt wie die Raumfahrt selbst. Es ging dabei nie nur um Prestige. Biesler, Jörg www.deutschlandfunk.de, Der Rest ist Geschichte

Hormone und Hysterie - Wie sich unser Blick auf die Menstruation verändert hat
Menstruierende Frauen sind unrein, gefährlich oder wahnsinnig, ihr Periodenblut ist giftig: Diese Menstruations-Mythen haben ihre Wurzeln in der Antike. Jahrhundertelang wurden sie weitergesponnen - und dienten auch dazu, Frauen zu benachteiligen. Pulz, Magdalena

Die Atombombe - Wie die schlimmste Waffe aller Zeiten Frieden schaffen soll
Russlands Präsident Wladimir Putin droht offen mit seinen Atombomben. Seither diskutiert der Westen wieder über nukleare Abschreckung. Können Atomwaffen tatsächlich Kriege verhindern? Die Geschichte liefert Antworten. Biesler, Jörg

Macht der Medaillen - Warum Olympia politisch ist
Die besten Athleten der Welt messen sich im Wettkampf und stärken so Frieden und Völkerverständigung - das ist die olympische Idee. Doch die Geschichte zeigt: Olympische Spiele waren oft staatliche Leistungsschau oder Propagandabühne für Diktatoren. Pulz, Magdalena

Vegetarismus - Kein Blut auf dem Teller
Je mehr Fleisch, desto besser: Das galt lange, denn tierisches Eiweiß war ein Erfolgsfaktor für die menschliche Entwicklung. Als frühe Vegetarier im 19. Jahrhundert trotzdem darauf verzichteten, ging es ihnen nicht ums Tierwohl. Pulz, Magdalena

Apartheid - Südafrikas Geschichte, Israels Gegenwart?
Rassismus per Gesetz: Das galt in Südafrika während der Apartheid. Schwarze wurden als Menschen zweiter Klasse gesehen und von Weißen entrechtet, doch dieses Regime ist lange Geschichte. Heute wirft Südafrika einem anderen Land Apartheid vor: Israel. Biesler, Jörg

Dschihadismus - Mit dem Bombengürtel ins Paradies
Islamistische Terroristen wollen töten - und glauben, ihrem Gott damit zu gefallen. Sie berufen sich auf ein jahrhundertealtes religiöses Konzept: den Dschihad, den heiligen Krieg. Experten warnen, denn die Gefahr durch Dschihadisten nimmt wieder zu. Pulz, Magdalena

Ukraine - Der lange Kampf um Unabhängigkeit
Die Ukraine als eigenständige Nation gibt es nicht: Das behauptet Russlands Präsident Putin. So rechtfertigt er seinen Angriffskrieg gegen das Land. Doch die Aussage ist falsch - der Kampf der Ukraine um Unabhängigkeit hat eine lange Geschichte. Biesler, Jörg

Geschichte der Steuern - Rüstung, Rente und Regierungskrach
Wie viel Geld darf der Staat seinen Bürgern abnehmen und wofür soll er es ausgeben: für Schulen, Straßen oder Soldaten? Diese Debatte ist so aktuell wie historisch und in Kriegszeiten wird sie besonders kontrovers geführt. Denn Kriege sind teuer. Biesler, Jörg

Hörtipp - Doku-Serie „Rechtsextreme vor Gericht“
„Der Rest ist Geschichte“ macht diese Woche Pause! Aber wir empfehlen Euch die neue DLF-Doku-Serie „Rechtsextreme vor Gericht“: Beobachtungen unter anderem aus dem Prozess gegen den Mörder von Walter Lübcke, dem früheren Kasseler Regierungspräsidenten. Schwesinger, Marie

Geschichte der EU - Friedensprojekt mit Hintergedanken
Wohlstand schaffen, auf den Kalten Krieg reagieren und Deutschlands Rüstung kontrollieren: Das waren die Ziele, als sich einige Länder Westeuropas nach 1945 auf eine Zusammenarbeit verständigten. Es war das Fundament der heutigen Europäischen Union. Pulz, Magdalena www.deutschlandfunk.de, Der Rest ist Geschichte

Bewunderte Mörder? - Deutschlands Verhältnis zum Linksterrorismus der RAF
Die Rote Armee Fraktion war eigentlich schon Geschichte. Jetzt ist sie wieder in den Schlagzeilen, weil eine mutmaßliche RAF-Terroristin nach Jahrzehnten im Untergrund geschnappt wurde. Viele schauen mit morbider Faszination auf den linken Terror. Biesler, Jörg www.deutschlandfunk.de, Der Rest ist Geschichte

Geschichte eines Materials - Wie Plastik zum Problem wurde
Obwohl das Problem von Plastik schon lange bekannt ist, wurde der Siegeszug des unvergänglichen Materials nicht gestoppt. Die Geschichte von Zelluloid, Bakelit und PVC ist auch eine Geschichte des Wegsehens. Pulz, Magdalena

Sanktionen - Wenn Staaten strafen
Iran, Russland und Nordkorea gehören zu den Ländern, die aktuell unter Sanktionen stehen. Sanktionen sind ein politisches Druckmittel: vom Wirtschaftsembargo bis zum Ausschluss von Olympischen Spielen. Die Geschichte zeigt, dass das gelingen kann. Biesler, Jörg www.deutschlandfunk.de, Der Rest ist Geschichte

Gewerkschaften - Der lange Kampf ums Arbeitsrecht
Gewerkschaften sind vor allem dann in den Schlagzeilen, wenn sie zu Streiks aufrufen oder Tarifverhandlungen ins Stocken geraten. Historisch haben sie bedeutenden Anteil an der Durchsetzung von Arbeitsrechten. Doch bis dahin war es ein langer Weg. Tran, Anh

Die Hisbollah - Irans Faust an Israels Grenze
Die islamistische Hisbollah im Libanon könnte für Israel noch gefährlicher werden als die Hamas in Gaza. Der Iran hat die Hisbollah mit Geld, Waffen und Ideologie ausgestattet. Die Macht der Miliz ist auch Folge der iranischen Revolution von 1979. Biesler, Jörg

Geschichte der Pflege - Wie Fürsorge zum Beruf wurde
In Deutschland gibt es zu wenig Pflegekräfte. Das wird noch schlimmer, wenn die Babyboomer alt und gebrechlich werden. Der Pflegeberuf wird oft unterschätzt: Lange Zeit waren es Ehefrauen und Töchter, die diese Arbeit still und gratis erledigten. Tran, Anh

Holocaust und Kolonialismus - Warum es einen neuen Historikerstreit gibt
Israel steht wegen des Gazakrieges derzeit in der Kritik: Manche Linke sprechen von Kolonialismus, Brasiliens Präsident ließ sich gar zu einem Holocaustvergleich hinreißen. Das erinnert an einen alten Streit über die Beispiellosigkeit des Holocaust. Biesler, Jörg

Biomedizin - Warum Deutschland einen Sonderweg geht
Schafe und Hunde kann man heute schon klonen, auch an menschlichen embryonalen Stammzellen wird geforscht. Mediziner hoffen auf Therapien für bisher unheilbare Krankheiten. Deutschland ist bei der Biomedizin sehr restriktiv, aus historischen Gründen. Tran, Anh
Der Rest ist Geschichte - Der neue Podcast über Historisches im Heute
Lange her, aber nicht vorbei: Jede Woche stellen wir Fragen der Gegenwart und suchen Antworten in der Geschichte. Dabei lernen wir Menschen kennen, deren Leben so heldenhaft, verwerflich oder traurig war, dass wir sie nicht vergessen dürfen. Brose, Maximilian www.deutschlandfunk.de, Der Rest ist Geschichte























